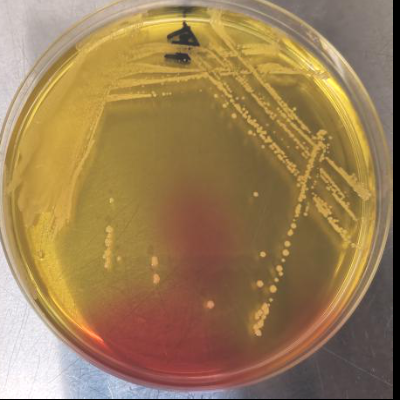
2970415 (2).png
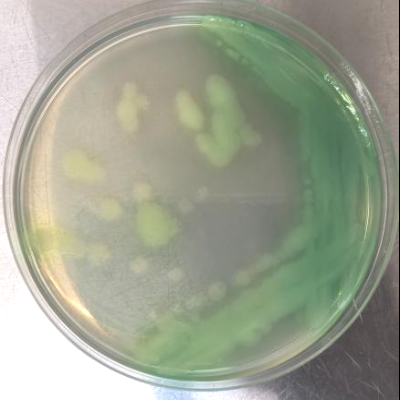
2970415 (3).png

单个细菌微小且透明,在光学显微镜下难以将其与背景区分而看清,为了便于鉴别,需要给它们染上颜色。常用的染色法有单染色法和复染色法两种。单染色法是以一种染料对细菌标本进行染色,可观察细菌的形态、大小及排列。复染色法是用两种或两种以上的染料先后对细菌标本进行染色,染色后除可观察细菌的形态、大小、排列外,还有鉴别细菌的作用,最常用的是革兰染色法。革兰染色法是丹麦科学家革兰姆于1884年首创。首先用结晶紫液加碘液染色,再用脱色剂或95%乙醇脱色,最后用番红液复染色。经过这样的处理,可以把细菌分成两大类,凡能染成紫色的,叫革兰氏阳性菌;凡被染成红色的,叫革兰氏阴性菌。这两类细菌在生活习性和细胞组成上有很大差别,医生常依据细菌的革兰氏染色结果来选用药物,诊治疾病。
革兰氏阴性菌 革兰氏阳性菌
细菌家族的成员,如果固定在一个地方生长繁殖,就形成了用肉眼能看见的小群体,叫菌落。有的菌落呈现无色的状态,有的菌落带有绚丽的色彩,如铜绿假单胞菌的菌落是绿色的,葡萄球菌的菌落是金黄色的。细菌菌落的形状、大小、厚薄和颜色等特点,是鉴别各种菌种的依据之一。弗莱明就是通过观察到金黄色的葡萄球菌,发现了“吃”掉葡萄球菌的青霉素,划时代地揭开了抗生素的秘密。

注:文章参考《奇妙的微观世界》(作者:蓝必登;来源:《第二课堂(初中)》2008年03期);图片来源于实验室数据。










发表评论